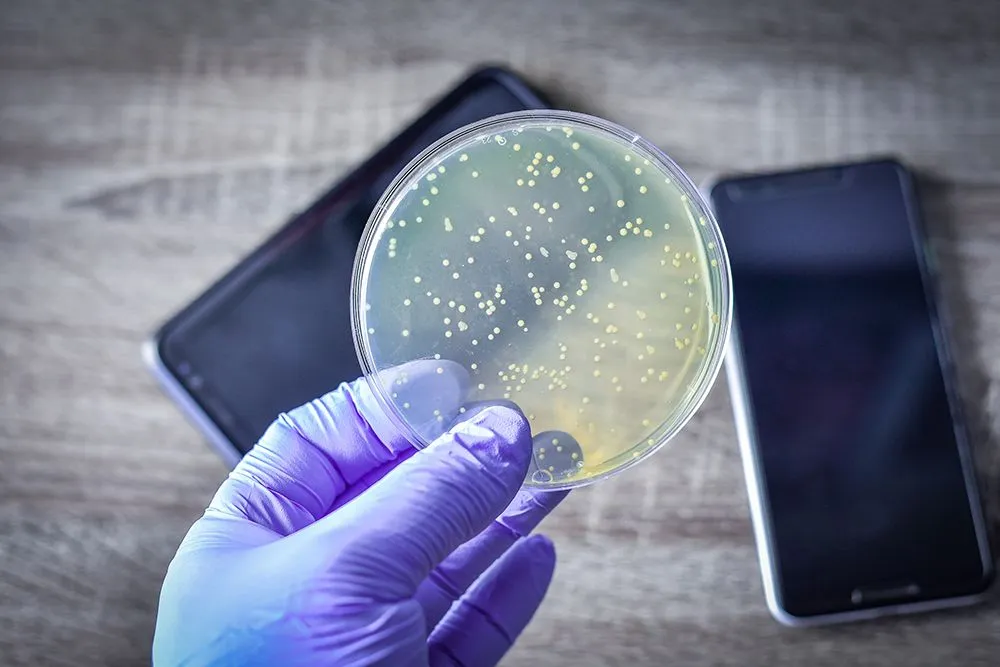
Mobile phones are carriers of many species of bacteria and can be easily transmitted (Credits: manjurulhaque/Envato Elements)

Research shows that phones are some of the dirtiest objects we interact with each day. They carry more bacteria than many other surfaces, and are probably dirtier than your toilet seat, especially if you clean your toilet seat more often than your phone.
We’re attached to our mobile phones way more than we care to admit. We use them everywhere; at work, while commuting, at the dinner table, in bed, sitting, standing and every other possible position. As if this wasn’t enough, many of us have also started taking our phones to the loo.
Mobile phones have taken over the job of a newspaper or magazine that some would take to pass the time while doing their “business”.

These mobile phones that we hold so close to our hearts (and our faces), hides a dirty secret in plain sight. What if I told you that they are dirtier than toilet seats?
Recommended Video for you:
Evidence Of Bacterial Presence Of Phones
There are trillions of bacteria present in the human body. For every cell present in our body, there are 10 bacteria. Considering the overwhelming existence of bacteria around us, the fact that they also loom on our phone screens should come as no surprise.
A recent study found more than 17,000 bacterial gene copies on the 17 sample phones of male and female secondary school students.
This makes phones one of the nastiest things we handle every day.
However, if there are already bacteria living on our skin, then why is the bacteria on phones such a big deal?
The Skin Microbiome

Just like in our guts, certain groups of bacteria live peacefully on our skin. One such “good” bacteria is Staphylococcus epidermidis. A study found that this bacteria produces an enzyme (sphingomyelinase) that helps maintain a healthy outer layer of skin.
On the contrary, bacteria such as Propionibacterium acnes are the culprits behind those painful and unsightly pimples many of us get.
Considering how our phones are practically stuck in our hands these days, it’s fairly easy for such bacteria to jump back and forth from the phone to our skin.
But are all the bacteria on the phone dangerous?
Are Phones Dirtier Than Toilet Seats?
According to a review of 56 papers on the bacteria found on phones, there were a few bacterial species most commonly found on mobile phones.
These include E.coli, Staphylococcus aureus, Coagulase Negative Staphylococci (CoNS), Pseudomonas and Salmonella species, just to name a few. These are considered to be opportunistic pathogens, which means that under normal conditions, they don’t pose any threat except to people with weak immunity.

Escherichia coli (E.coli), also known as fecal coliform bacteria, is one of the most predominant bacteria found on cell phones. You can make an educated guess by looking at its name that it relates to feces. E. coli is present in the intestines of people and animals, and found in fresh fecal matter. Thus, its presence on your phone means there is a good chance that some amount of poop is also present on your phone. Think about this the next time you take your phone with you to the toilet.
Staphylococcus aureus was present in around 12.8% of cultures. It is harmless in most cases, but is known to cause health issues ranging from mild skin infection to pneumonia when it enters the body.
Staphylococcus epidermidis and Staphylococcus saprophyticus are naturally found on the skin and mucous membranes of the skin. Under appropriate conditions, such as the right temperature, amount of moisture, and inadequate cleaning of the phone surface, they turn pathogenic and cause diseases.
Lastly, apart from bacteria, fungi act as occasional contaminants of cell phones. Fungi can cause skin rashes, while mold tends to attack the respiratory system, causing respiratory distress.
Even after accepting the fact that there are legions of bacteria present on cell phones, can they really be dirtier than a toilet?
According to several popular magazines, they can be. Dr. Charles Gerba corroborated this for the University of Arizona blog and USA Today, providing the statistic that mobile phones are 10 times dirtier than a toilet seat. Dr. Gerba asked in the University of Arizona blog, “When’s the last time you cleaned your cellphone?”
Several other popular new organizations have stated that phones top the list of the dirtiest objects around us. This claim, when compared to various other surfaces, such as the tables and chairs around us, research corroborates. However, there are no direct studies comparing the bacterial load on a phone with that of a toilet seat.
The reasoning provided in publications is that we touch our phones frequently, but rarely clean them, whereas we go to the toilet when necessary, but clean and disinfect those surfaces frequently. The toilet is a disgusting place that needs cleaning, but the phone…? It doesn’t look all that dirty (even though many of us are taking it to the “bathroom” with us), but that’s clearly not the whole story.
Is There Anything Dirtier Than A Mobile Phone?
Now that we’ve explored just how dirty phones are, is there anything that beats phones in this foul race?
What about money? A small piece of paper or metal with significant value that gets handed down so many times. That’s bound to be dirtier, right?
It won’t be accurate to say one is “dirtier” than the other. That being said, money is equally (if not more) contaminated by microbes as compared to phones.
$1 bills were swabbed and examined by researchers in New York City to prove this theory. Apart from finding fairly obvious human DNA on the currency notes, the scientists also found DNA of pets and wild animals like wild boar and grey wolves.

There were also different species of fungi, common skin bacteria like Staphylococcus epidermis and oral bacterium like Streptococcus oralis. Another study identified the presence of Staphylococcus aureus, Salmonella species and Escherichia coli on coins.
To make things more interesting, many studies also found drug residue on money. A study found traces of cocaine, heroin, THC and MDMA on UK banknotes. In the US, 92% of dollar bills had traces of cocaine, along with heroin, morphine, methamphetamine and amphetamine.
Conclusion
At the end of the article, we must ask the most important question, why does it matter which surfaces are the dirtiest?
First, it helps us predict what to keep clean to prevent sickness. This becomes especially important in hospitals; doctors and nurses do use their phones, and they could carry microbes from the hospital out or vice versa. This was also important during the COVID-19 pandemic, in order to keep the virus from spreading.
Second, it helps epidemiologists figure out how diseases spread, and most importantly, how antibiotic-resistant microbes could interact and spread. This becomes pertinent because we have already found Methicillin-resistant Staphylococcus aureus (MRSA) on phones.
All that said, no matter how much you try, bacteria will surround you. Even with all the disinfectants in the world, bacteria will find their way back to your phone. Bacteria live peacefully on the phone because cleaning it is a tricky task, so they are rarely cleaned. Also, the warm surface of the phone makes it a cozy place for bacteria to grow.
The least you can do is avoid being a “toilet texter” and think twice before scrolling through Instagram while eating. Detaching from your mobile a bit more often could be a great boon for both your physical and mental health!
References (click to expand)
- Is your cell phone really 10 times dirtier than a toilet seat?.
- Sleeman, Richard, et al. “Peer Reviewed: Drugs on Money.” Analytical Chemistry, vol. 72, no. 11, June 2000, p. 397 A-403 A. DOI.org (Crossref), https://doi.org/10.1021/ac002826p.
- Hewitt, K. M., Gerba, C. P., Maxwell, S. L., & Kelley, S. T. (2012, May 30). Office Space Bacterial Abundance and Diversity in Three Metropolitan Areas. (J. Ravel, Ed.), PLoS ONE. Public Library of Science (PLoS).
- Your smartphone is 7 times dirtier than your toilet. Here's ....
- Selim, H. S., & Abaza, A. F. (2015). Microbial contamination of mobile phones in a health care setting in Alexandria, Egypt. GMS Hygiene and Infection Control; 10:doc03; ISSN 2196-5226.
- Olsen, M., Campos, M., Lohning, A., Jones, P., Legget, J., Bannach-Brown, A., … Tajouri, L. (2020, May). Mobile phones represent a pathway for microbial transmission: A scoping review. Travel Medicine and Infectious Disease. Elsevier BV.












